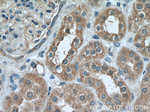
IkB beta Antibody in Immunohistochemistry (Paraffin) (IHC (P))

Search
Proteintech
IkB beta Polyclonal Antibody
{{$productOrderCtrl.translations['antibody.pdp.commerceCard.promotion.promotions']}}
{{$productOrderCtrl.translations['antibody.pdp.commerceCard.promotion.viewpromo']}}
{{$productOrderCtrl.translations['antibody.pdp.commerceCard.promotion.promocode']}}: {{promo.promoCode}} {{promo.promoTitle}} {{promo.promoDescription}}. {{$productOrderCtrl.translations['antibody.pdp.commerceCard.promotion.learnmore']}}
产品信息
12660-1-AP
种属反应
宿主/亚型
分类
类型
抗原
偶联物
形式
浓度
规格
纯化类型
保存液
内含物
保存条件
运输条件
产品详细信息
Immunogen sequence: MAGVACLGK AADADEWCDS GLGSLGPDAA APGGPGLGAE LGPGLSWAPL VFGYVTEDGD TALHLAVIHQ HEPFLDFLLG FSAGTEYMDL QNDLGQTALH LAAILGETST VEKLYAAGAG LCVAERRGHT ALHLACRVGA HACARALLQP RPRRPREAPD TYLAQGPDRT PDTNHTPVAL YPDSDLEKEE EESEEDWKLQ LEAENYEGHT PLHVAVIHKD VEMVRLLRDA GADLDKPEPT CGRSPLHLAV EAQAADVLEL LLRAGANPAA RMYGGRTPLG SAMLRPNPIL ARLLRAHGAP EPEGEDEKSG PCSSSSDSDS GDEGDEYDDI VVHSSRSQTR LPPTPASKPL PDDPRPV (1-356 aa encoded by BC015528)
靶标信息
The NF-kB/Rel transcription factors are present in the cytosol in an inactive state, complexed with the inhibitory IkB proteins. Most agents that activate NF-kB do so through a common pathway based on phosphorylation-induced, proteasome-mediated degradation of IkB. The key regulatory step in this pathway involves activation of a high molecular weight IkB kinase (IKK) complex whose catalysis is generally carried out by three tightly associated IKK subunits. IKK alpha and IKK beta serve as the catalytic subunits of the kinase and IKK gamma serves as the regulatory subunit. Activation of IKK depends upon phosphorylation at Ser177 and Ser181 in the activation loop of IKK beta (Ser176 and Ser180 in IKK alpha), which causes conformational changes, resulting in kinase activation.
仅用于科研。不用于诊断过程。未经明确授权不得转售。
生物信息学
蛋白别名: I kappa B beta; I-kappa-B-beta; ikappaBbeta; IKB B; IKB beta; IkB-B; ikB-beta; IkBbeta; NF kappa BIB; NF-kappa-B inhibitor beta; NF-kappa-BIB; NFKBIB; nuclear factor of kappa light polypeptide gene enhancer in B-cells inhibitor, beta; Thyroid receptor; Thyroid receptor-interacting protein 9; TR-interacting protein 9; TRIP 9; TRIP-9; unnamed protein product
基因别名: IKBB; NFKBIB; TRIP9
UniProt ID: (Human) Q15653
Entrez Gene ID: (Human) 4793